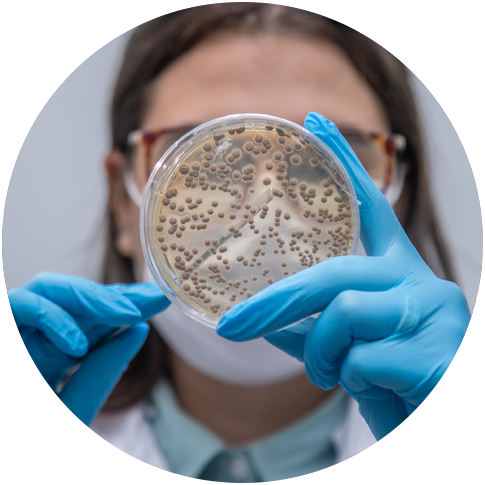

My roots, new stories.
With deep roots in research and innovation in the field, Vittia has become a national benchmark in biological defenses and plant nutrition. Our commitment is to contribute to task performance with sustainable, effective, and technological solutions, supported by ethics, knowledge, and experience.
We offer a complete and integrated portfolio that strengthens productivity and profitability, while contributing to the construction of increasingly sustainable agriculture.
We are proud to say that all our roots are here.